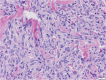

Hypoglycemia mediated by paraneoplastic production of Insulin like growth factor-2 from a malignant renal solitary fibrous tumor - clinical case and literature review
- PMID: 24934576
- PMCID: PMC4067084
- DOI: 10.1186/1472-6823-14-49
Hypoglycemia mediated by paraneoplastic production of Insulin like growth factor-2 from a malignant renal solitary fibrous tumor - clinical case and literature review
Abstract
Background: Hypoglycemic episodes are infrequent in individuals without a history of diabetes mellitus or bariatric surgery. When hypoglycemia does occur in such individuals, an uncommon but important diagnosis to consider is non-islet cell tumor hypoglycemia (NICTH). We report a case of NICTH associated with paraneoplastic insulin-like growth factor-2 (IGF-2) production and review current relevant medical literature.
Case presentation: A 60 year old male with no relevant past medical history was referred to the endocrinology clinic with 18 month history of episodic hypoglycemic symptoms and, on one occasion was noted to have a fingerstick glucose of 36 mg/dL while having symptoms of hypoglycemia. Basic laboratory evaluation was unrevealing. Further evaluation however showed an elevated serum IGF-2 level at 2215 ng/mL (reference range 411-1248 ng/mL). Imaging demonstrated a large right suprarenal mass. A right nephrectomy with resection of the mass demonstrated a malignant solitary fibrous tumor. Post resection, the patient's IGF-2 levels normalized and hypoglycemic symptoms resolved.
Conclusion: Due to the structural and biochemical homology between IGF-2 and insulin, elevated levels of IGF-2 can result in hypoglycemia. A posttranslational precursor to IGF-2 known as "big IGF" also possesses biologic activity. Review of recent reported cases of NICTH identified widespread anatomic locations and varied pathologic diagnoses of tumors associated with paraneoplastic production of IGF-2 causing hypoglycemia. Definitive management of hypoglycemia associated with paraneoplastic production of IGF-2 consists of resection of the tumor responsible for IGF-2 production. Accumulating literature provides a firm basis for routine IGF-2 laboratory evaluation in patients presenting with spontaneous hypoglycemia with no readily apparent cause.
Figures
References
Publication types
MeSH terms
Substances
Grants and funding
LinkOut - more resources
Full Text Sources
Other Literature Sources
Medical
Miscellaneous